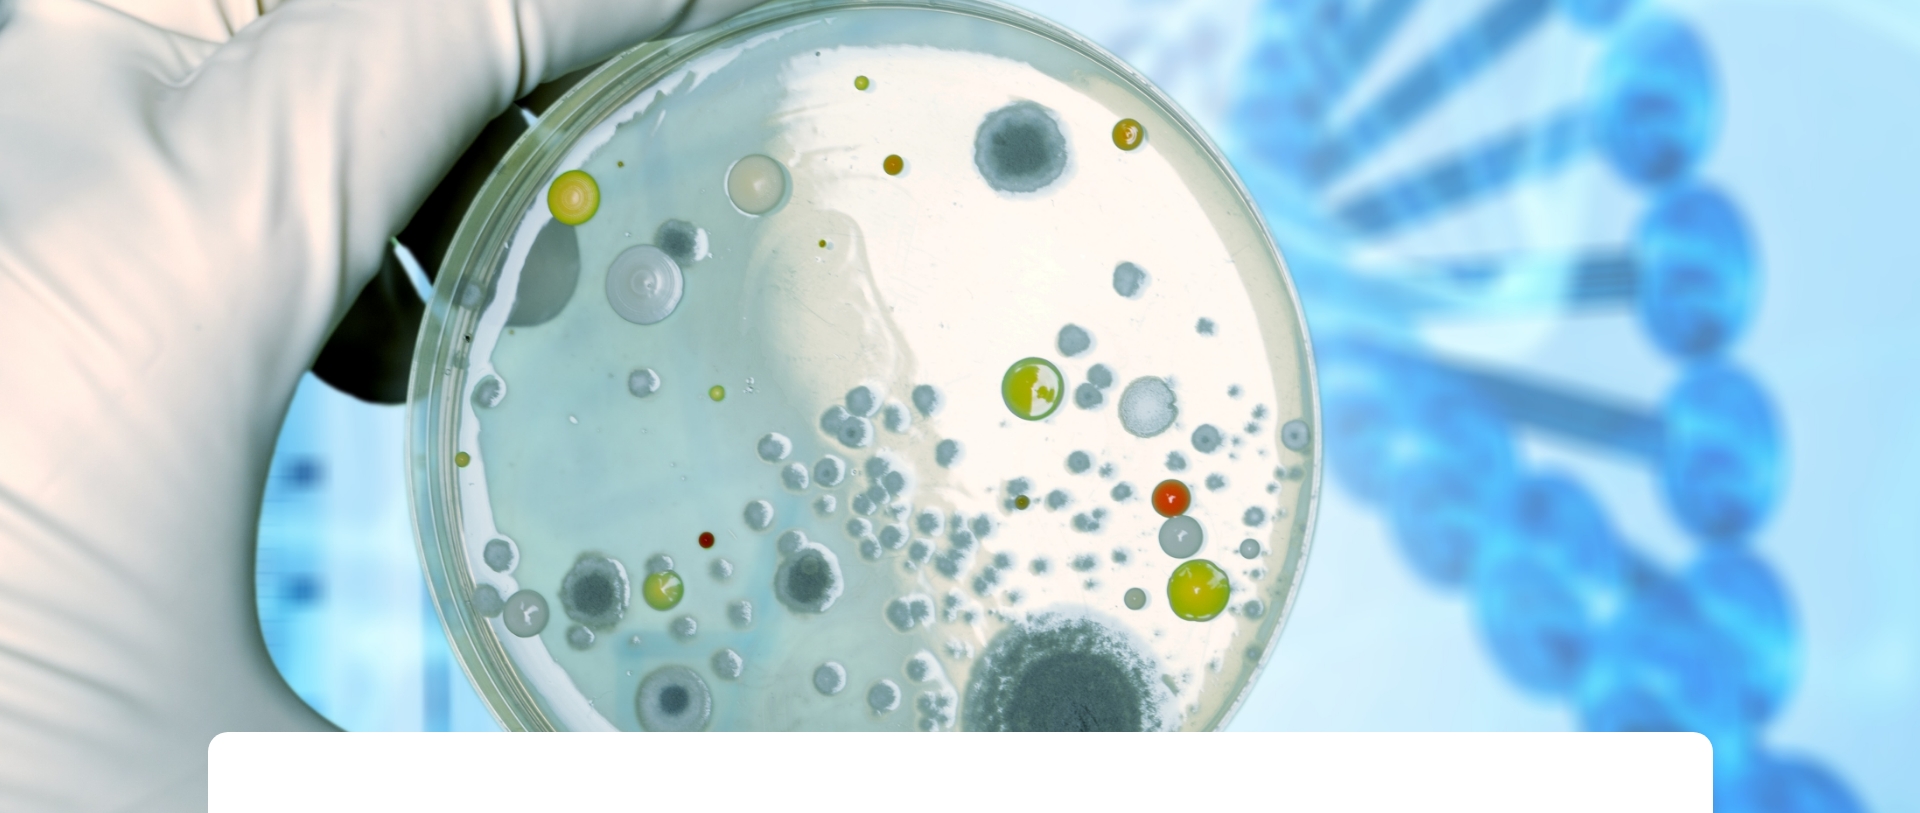
Microbiología

Microbiología
Contamos con profesionales altamente especializados en el área de microbiología, lo que nos convierte en un laboratorio altamente competente en esta especialidad bioquímica.
Se realiza toma de muestra y cultivos de muestras biológicas, que contemplan la búsqueda, aislamiento e identificación de bacterias, hongos y parásitos tanto en pacientes ambulatorios como en inmunocomprometidos.
Realizamos pruebas de susceptibilidad antimicrobiana en estos patógenos.
Además, se realiza el diagnóstico microbiológico a través de técnicas de biología molecular (infectología molecular).
Citología
La citología es un método altamente sensible y específico que se ocupa de la detección de lesiones neoplásicas y sus estadios precursores. A través del tamizaje de las muestras por la conocida técnica Papanicolaou cumplimos con los requisitos de simplicidad, regularidad, costo, precisión y sensibilidad.
Estamos orgullosos de poder aportar al diagnóstico de cáncer de cuello uterino y también aplicar este método a otras áreas, como tracto respiratorio, urinario, líquidos de punción y lesiones cutáneas.